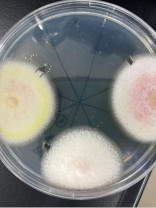
資源生物科学基盤実験実習

名古屋大学 R.I.特派員

名古屋大学 農学部 2年 R.I.特派員

ひとり暮らし
趣味:料理(自炊、お弁当づくりを頑張っています!)
※2023年にお書きいただいた内容です。
講義、ゼミ、研究内容について
資源生物科学基盤実験実習
この実習では、研究室に配属されたときのために、生物実験の基本を実際の実験を通して学びます。採集した土壌からコロニーを培養して観察したり、マウスを解剖し、組織切片をつくって観察したりするなど、学生主体で実験を進めるのでとても楽しいです。また、タンパク質の電気泳動やPCR解析、ショウジョウバエの交配実験など、大学受験のときに紙上で必死に学んだことが実際に経験できて感慨深いものもあります。実験レポート課題は大変ですが、友達と教えあったり、TA(院生のサポーター)に助けてもらったりしながら楽しんでやっています!
課外活動、大学施設などについて
まかない♡

私は、和食料理店と学食で週2回ずつアルバイトをしています。和食料理店では、接客と盛り付けや仕込みのお手伝いをしています。高級店なので、マナーが身につきます。そして勤務終了後は、料理長がバイト一人一人の好みに合わせて高級食材を使ったまかないを振舞ってくれます!豪華すぎて困るくらいです・・・。学食では、レジを担当しています。2時間弱で600人以上が利用するので、早打ちを極めています。こちらは残った料理が食べ放題なので、アレンジしたりして楽しんでいます。バイト終わりのまかないが幸せなので、仕事も頑張れます!
ぼくのわたしの時間割
| 月曜日 | 火曜日 | 水曜日 | 木曜日 | 金曜日 | 土曜日 | |
|---|---|---|---|---|---|---|
| 1限 | 生命系物理工学 オンライン |
生物化学2 対面形式 |
英語上級 対面形式 |
環境学入門 対面形式 |
||
| 2限 | 遺伝学 対面形式 |
有機化学2 対面形式 |
現代社会の食と農 オンライン |
|||
| 3限 | 資源生物科学基盤実験実習 対面形式 |
生態学 対面形式 |
動物生理学1 対面形式 |
|||
| 4限 | 分類・形態学 対面形式 |
農学セミナー1 対面形式 |
||||
| 5限 | ||||||
| 6限 |
※2023年度前期の時間割
私の学部はほぼ必修科目なので、時間割をカスタマイズする余地はありませんでした。木・金は1限のみだったので、ランチのアルバイトを入れていました。1限がない、もしくはオンデマンドの日は洗濯や掃除をしていました。
ぼくのわたしのおサイフ事情
| 収入 | 支出 | ||
|---|---|---|---|
| 仕送り、お小遣い | 80,000 円 | 家賃 | 51,000 円 |
| 奨学金 | 0 円 | 水光熱費 | 10,000 円 |
| アルバイト | 45,000 円 | 食費・外食費 | 12,000 円 |
| その他 | 0 円 | 通信費(電話・インターネット代) | 4,000 円 |
| 交通費 | 1,000 円 | ||
| 勉学費 | 0 円 | ||
| 交際費(サークル活動費等)・趣味 | 3,000 円 | ||
| 衣料・ファッション | 0 円 | ||
| 貯蓄 | 42,000 円 | ||
| 雑費・その他 | 2,000 円 | ||
| 収入総額 | 125,000 円 | 支出合計 | 125,000 円 |
※1か月の平均収支
電気をこまめに消す、大学で充電する、暑い時間帯は外出するなど節電を心がけています。また、バイトのまかないがある日以外は自炊をし、大学での昼食はお弁当にしています。
将来の夢 ~ 夢に向かって大学生活の中でがんばっていること
研究員
まずは大学院に進学する予定なので、その後のことはまだ漠然としていますが、食や植物に興味があるので、食品会社か種苗会社、もしくは大学の研究員になりたいと考えています。累積GPAの高い人(成績の良い人)から研究室を選ぶ権利や海外研修の奨学金がもらえるので、日々の勉強を頑張っています。
メッセージ ~ 高校との違い、先輩として高校生・受験生に伝えたいこと
健康第一!
やりたいこととやるべきことがありすぎて、大学生活は思っていたよりもとても忙しいです。でもそれだけ充実しているということでもあるし、何をどれだけやるか自分で組み立てられるので毎日楽しいです。私は受験期に体調を崩してしまったのを引きずっていて、やりたいことが思いっきりできないことがあったので、みなさんは体を大切にしながら頑張ってください!また、1年生のはじめは時間に余裕があるので、要領がつかめなくて無駄に過ごしてしまうことのないように、入学前に授業のシラバスや口コミ、部活やサークルなどについてよく調べたり、アルバイトや免許取得の計画を立てておくといいと思います。



